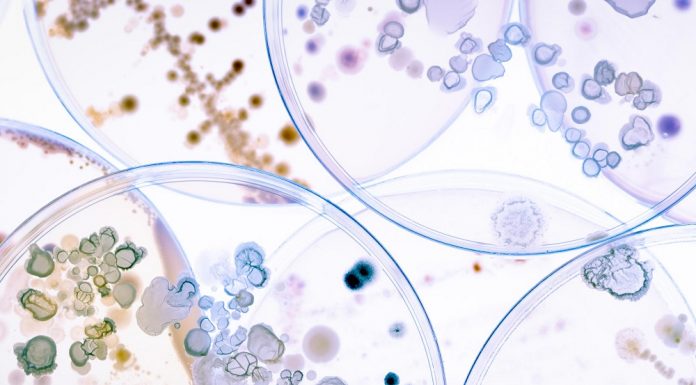

Mnoge rešitve se vračajo k naravi in učinkovine z izrazitim antibiotičnim delovanjem iščejo v rastlinskem svetu. Kljub številnim poskusom in intenzivnim raziskavam pa preboja (še) ni na vidiku. Foto: Bigstock
Od iznajdbe antibiotikov,...
Ljudje se zelo zanašamo na rutino, ki jo izvajamo natančno tako, kot smo se je naučili, Ko so nam ponujene drugačne možnosti, jih težko upoštevamo, tudi, če so bolj učinkovite. Foto: Bigstock
Kreativno...
Na to, kako uspešna je bakterija A. muciniphila v našem črevesju, lahko vplivamo sami: uživamo hrano, ki spodbuja njeno rast in ji omogoča poselitev večjega dela sluznice. Foto: Bigstock
Zdi se, da metabolni...
Predvidevamo, da se med spanjem spontano predvajajo stari in novi spomini, kar preprečuje pozabljanje in poveča zmožnost priklica," pojasnjuje prvopodpisani avtor objave prof. dr. Maxim Bazhenov iz UC San Diego. Foto: Bigstock
Od...
Mali možgani so izjemno pomembni tudi za spoznavne sposobnosti in kompleksne nemotorične funkcije. Foto: Bigstock
Mali možgani igrajo pri umskih sposobnostih in socialnih veščinah bolj pomembno vlogo, kot so menili doslej. Splošno sprejeta...
Pomanjkanje železa je vzrok za sindrom nemirnih nog, ki je pogosto spregledana in napačno zdravljena bolezen, saj je običajna preiskava krvi ne odkrije. Potrebno je izmeriti raven feritina (in ne zgolj hemoglobina) v krvi. Foto:Bigstock
Posebno pozornost je poleg kože treba namenjati tudi nohtom, saj spremembe na nohtih nakazujejo tudi na druga obolenja. Foto: Bigstock
Koža je pomemben organ; med drugim skrbi za najobsežnejšo zaščito našega telesa pred...
Če bi lahko vplivali na zdravje možganov prej, na primer v srednjih letih, bi to lahko spremenilo vse. Foto: Bigstock
Retrospektivna analiza, v kateri so podatke standardiziranega vprašalnika o stresu na delovnem mestu...
Jutra z okorelimi sklepi, ki jih šele razgibavanje spravi v normalno funkcioniranje, so vsakdanjik mnogih. Foto: Bigstock
Osteoartroza je najbolj razširjena kronična revmatska bolezen sklepov in hrbtenice. Je degenerativna, kar pomeni, da z...
Pristen nasmeh aktivira 10 odstotkov več obraznih mišic. Foto: Bigstock
Težko je prepoznati pravi nasmeh od lažnega ter pristno prijaznost od lažne - pa vendar se nam to v praksi dogaja vsak dan....